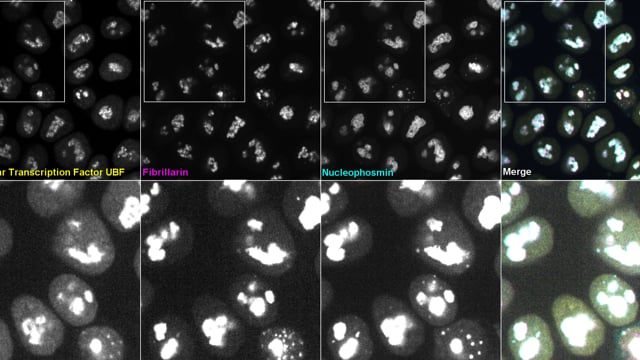
Video thumbnail

NCBI Isoforms:n |
crRNA Target Site:AACTGAAGTTCAGCGCTGTC / TCCAGGCTATTCAAGATCTC / CGAGGAGGTGGCTGGACAGC |
Linker: KPNSAVDGTAGPGSIAT / KPNSAVDGTAGPGSIAT / SG |
Cas9:Wildtype spCas9 |
AICS-0086
FBL in WTC-mEGFP (mono-allelic tag)
Single, mid-level plane of cells in a live hiPS cell colony expressing mEGFP-tagged fibrillarin, mTagRFP-T-tagged nucleophosmin, and HaloTag-tagged nucleolar transcription factor UBF visualized with ligand Janelia Fluor 646 (Promega). Panels show individual channels for fibrillarin, nucleolar transcription factor UBF, nucleophosmin, and an overlay of the three (counterclockwise from top right). Cells were imaged in 3D on a spinning-disk confocal microscope. Scale bar, 5μm.

EditingDesign
GenomicCharacterization
StemCellCharacteristics
mEGFP Insert

